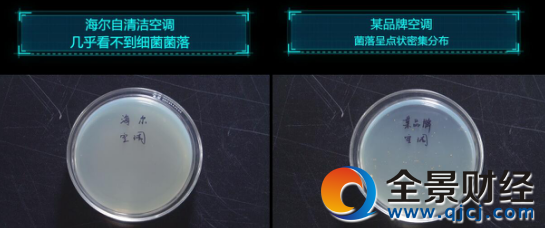

海尔智能自清洁空调能吹“无菌空气”
2月22日,海尔推出一则《真的吗》视频,通过换热器翅片细菌对比实验,验证了海尔智能自清洁空调能够吹出几乎无菌的空气。自空调诞生以来,脏空调造成的室内空气二次污染屡屡危害用户健康,海尔通过自清洁技术创新让用户呼吸到几乎无菌的空气,解决了这个问题。
视频中,记者带着“空调能吹无菌空气是真的吗”这一疑问走进实验室,通过对比实验验证了海尔智能自清洁空调能吹几乎无菌的空气。实验分别选取了使用时间均达到2个月普通空调和海尔智能自清洁空调换热器翅片,经过48小时细菌培养后,普通空调样本菌落呈点状密集分布,含有大量细菌。而海尔智能自清洁空调样本几乎未发现细菌菌落,能吹几乎无菌的空气。
由于空调换热器处于冷热空气交换的必经之地,经常有冷凝水附着,潮湿的环境容易滋生大量细菌,细菌通过空气传播,会侵犯人的皮肤、呼吸系统,以及会引起食物中毒、腹泻等消化道疾病,威胁消费者的健康。同时还会增加电量消耗,影响制冷效果,缩短使用寿命。
而海尔智能自清洁空调换热器表面应用6大专利自清洁技术之一的专利银离子抗菌涂层,抑菌率高达99.9%,可有效抑制能够引起腹泻、呕吐的金色葡萄球菌等病菌。不仅如此,通过自清洁专利冷膨胀技术,结霜时产生巨大膨胀力剥离空调换热器污垢,并利用化霜后产生的大量冷凝水冲刷,实现除尘抗菌,有效避免了脏空调造成的室内空气二次污染。
据了解,海尔智能自清洁空调上市1年半累计销量已突破300万套,随着能吹几乎无菌空气的特点被广泛认知,海尔智能自清洁将被更多用户认可,为用户提供更加健康的空气产品体验。
【关注微信公众号:石化宝(bweipan)手机也能炒白银原油,仅需8元即可参与,快来试试吧】
>更多相关文章
-
无相关信息
24小时热门资讯
热门推荐
酷图美文












